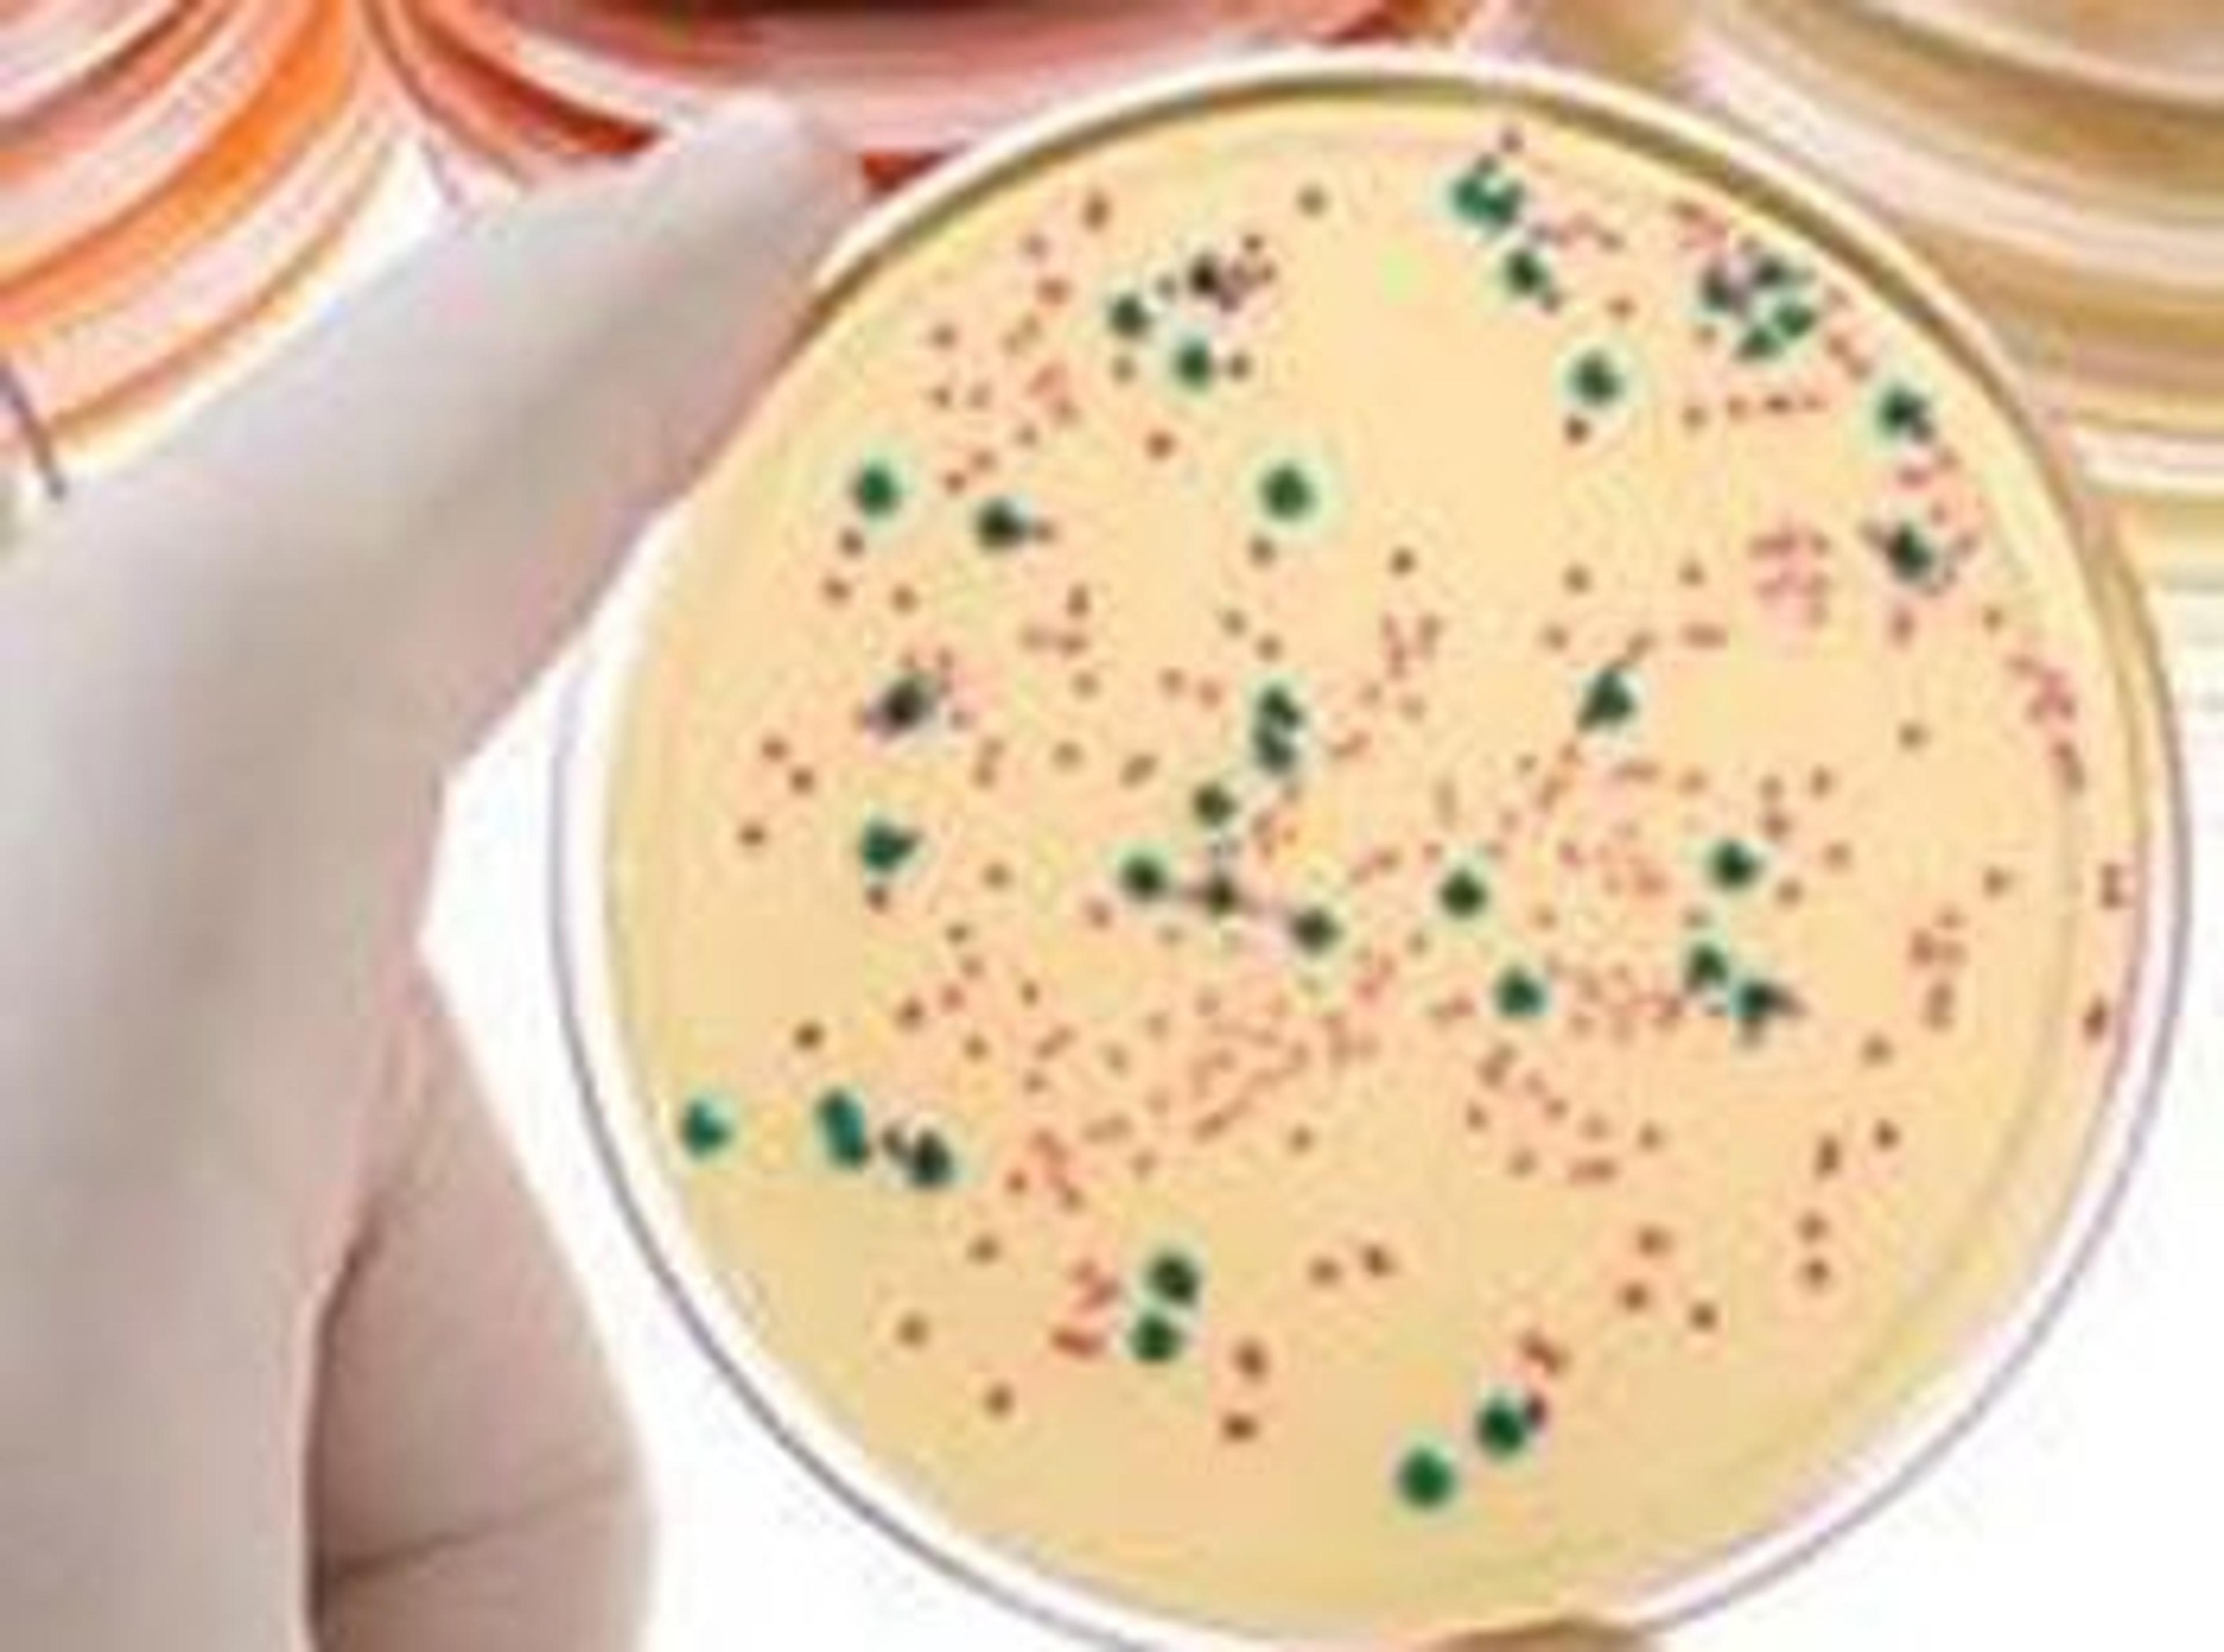

News & Articles
Selected Filters:
Repurposing Existing Drugs to Speed Up the Development of Therapies for Rare Muscular Dystrophies
Discover how a research group at the University of Geneva, Switzerland, is using an innovative approach to accelerate therapeutics through the drug development process
Workflow Questions Answered: Challenges with FFPE Samples in your NGS Workflows
By Guest Editor Jung Doh, Senior Applications Scientist, Beckman Coulter Life Sciences.
Discover SelectScience’s Highlights from Labvolution 2017
Fascinating video interviews with leading scientists, a tantalising glimpse into the future for labs and the Scientists' Choice Awards
New On-Demand Targeted Next-Generation Sequencing Panels for Inherited Disease Research Deliver User Customization Without High Upfront Cost
Thermo Fisher to introduce Ion AmpliSeq™ On-Demand product line of pre-tested gene targets and several other new Ion Torrent NGS offerings at ESHG 2017
Thermo Fisher Scientific Introduces Latest in Capillary Electrophoresis Technology with New Applied Biosystems™ SeqStudio™ Genetic Analyzer
New low throughput Sanger sequencing and fragment analysis platform offers trusted technology and workflow with all-in-one cartridge system and cloud connectivity
Merck Develops Alternative CRISPR Genome Editing Method
Creates method to rapidly deploy newly discovered bacterial CRISPR systems in disease-specific applications
Free Webinar – Automate Colony Picking and Forget About Toothpicks
Learn how to automate colony picking, eliminate picking errors and save time
Brain Cancer Discovery Reveals Clues in Quest for New Therapies
Researchers have pinpointed two key molecules that drive the growth of an aggressive type of adult brain cancer
How Revolutionary PCR Technology is Advancing Vital Cancer Research
Watch industry leading scientists discuss the very latest developments in cancer research, made possible with digital PCR technology